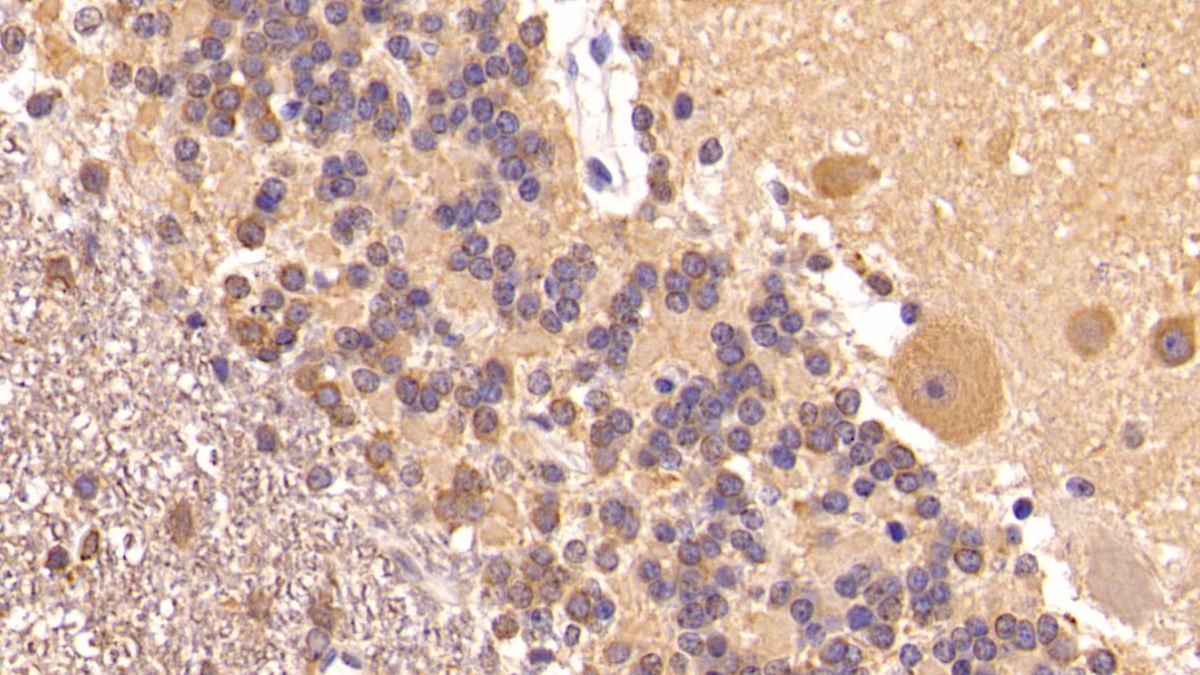

Monoclonal Antibody to Insulin Like Growth Factor 1 (IGF1) 

IGFI; IGF1A; IBP1; MGF; Somatomedin C; Mechano Growth Gactor
Overview
Properties
- Product No.MAA050Hu21
- Organism SpeciesHomo sapiens (Human) Same name, Different species.
- ApplicationsWB; IHC; ICC/IF
If the antibody is used in flow cytometry, please check FCM antibodies.
Research use only - DownloadInstruction Manual
- CategoryTumor immunityEndocrinology
- SourceMonoclonal antibody preparation, Host Mouse
- Ig Isotype IgG2b Kappa, Clone Number C10
- PurificationProtein A + Protein G affinity chromatography
- LabelNone
- Immunogen RPA050Hu01-Recombinant Insulin Like Growth Factor 1 (IGF1)
- Buffer Formulation0.01M PBS, pH7.4, containing 0.05% Proclin-300, 50% glycerol.
- TraitsLiquid, Concentration 1mg/mL
Sign into your account
Share a new citation as an author
Upload your experimental result
Review

Contact us
Please fill in the blank.
Specifity
The antibody is a mouse monoclonal antibody raised against IGF1. It has been selected for its ability to recognize IGF1 in immunohistochemical staining and western blotting.
Usage
Western blotting: 0.5-6µg/mL;
Immunohistochemistry: 5-20µg/mL;
Immunocytochemistry: 5-20µg/mL;
Optimal working dilutions must be determined by end user.
Storage
Store at 4°C for frequent use. Stored at -20°C in a manual defrost freezer for two year without detectable loss of activity. Avoid repeated freeze-thaw cycles.
Stability
The thermal stability is described by the loss rate. The loss rate was determined by accelerated thermal degradation test, that is, incubate the protein at 37°C for 48h, and no obvious degradation and precipitation were observed. The loss rate is less than 5% within the expiration date under appropriate storage condition.
Giveaways
Increment services
-
 Antibody Labeling Customized Service
Antibody Labeling Customized Service
-
 Protein A/G Purification Column
Protein A/G Purification Column
-
 Staining Solution for Cells and Tissue
Staining Solution for Cells and Tissue
-
 Positive Control for Antibody
Positive Control for Antibody
-
 Tissue/Sections Customized Service
Tissue/Sections Customized Service
-
 Phosphorylated Antibody Customized Service
Phosphorylated Antibody Customized Service
-
 Western Blot (WB) Experiment Service
Western Blot (WB) Experiment Service
-
 Immunohistochemistry (IHC) Experiment Service
Immunohistochemistry (IHC) Experiment Service
-
 Immunocytochemistry (ICC) Experiment Service
Immunocytochemistry (ICC) Experiment Service
-
 Flow Cytometry (FCM) Experiment Service
Flow Cytometry (FCM) Experiment Service
-
 Immunoprecipitation (IP) Experiment Service
Immunoprecipitation (IP) Experiment Service
-
 Immunofluorescence (IF) Experiment Service
Immunofluorescence (IF) Experiment Service
-
 Buffer
Buffer
-
 DAB Chromogen Kit
DAB Chromogen Kit
-
 SABC Kit
SABC Kit
-
 Long-arm Biotin Labeling Kit
Long-arm Biotin Labeling Kit
-
 Real Time PCR Experimental Service
Real Time PCR Experimental Service
Citations
- A microarray gene analysis of peripheral whole blood in normal adult male rats after long-term GH gene therapyPubMed: 20119855
- Characterization of the specific and sustained GH1 expression induced by rAAV2/1 in normal adult male ratsPubMed: 20204528
- The vagus nerve as a regulator of growth hormone secretionPubMed: 21056594
- Insulin-Like Growth Factor-1 (IGF-1) Reduces Ischemic Changes and Increases Circulating Angiogenic Factors in Experimentally - Induced Myocardial Infarction in RatsPubMed: 21651821
- Physical activity attenuates intermittent hypoxia-induced spatial learning deficits and oxidative stress.PubMed: 20224062
- The influence of nutrients, biliary-pancreatic secretions, and systemic trophic hormones on intestinal adaptation in a Roux-en-Y bypass modelPubMed: 20438940
- Serum insulin-like growth factor type 1 concentrations in healthy dogs and dogs with spontaneous primary hypothyroidismPubMed: 21546289
- Effects of monochromatic light on developmental changes in satellite cell population of pectoral muscle in broilers during early posthatch periodWiley: source
- Interleukin-6 Regulates the Expression of Hypothalamic Neuropeptides Involved in Body Weight in a Gender-Dependent WayWiley: source
- Insulin Like Growth Factor-1 (IGF-1) Causes Overproduction of IL-8, an Angiogenic Cytokine and Stimulates Neovascularization in Isoproterenol-Induced Myocardial Infarction in RatsMdpi: 8562
- Protective Effect of Amlodipine on Rat Bone Tissue after OrchidectomyKarger: 335491
- Maternal Glucocorticoid Treatment as a Model for Examining Foetal Gender-Specific Effects on the Bone Metabolism of Neonatal PigletsDegruyter: Source
- BMSCs reduce rat granulosa cell apoptosis induced by cisplatin and perimenopausePubMed: PMC3640998
- Evaluation of IGF-I levels and serum protein profiles of diabetic cats and dogsPubMed: PMC3232391
- A Combinatorial Relative Mass Value Evaluation of Endogenous Bioactive Proteins in Three-Dimensional Cultured Nucleus Pulposus Cells of Herniated Intervertebral Discs: Identification of Potential Target Proteins for Gene Therapeutic ApproachesPlosone: Source
- Porcine follicular fluid concentration of free insulin-like growth factor-I collected from different diameter ovarian folliclesScielo: Source
- EVALUATION OF PHYSICO-CHEMICAL PROPERTIES OF COLOSTRUM SUPPLEMENTED DAHIIjfans: Source
- Role of insulin-like growth factor-I and follicular fluid from ovarian follicles with different diameters on porcine oocyte maturation and fertilization in vitroScienceDirect: S0093691X13001659
- Electrochemical immunosensor for the determination of insulin-like growth factor-1 using electrodes modified with carbon nanotubes–poly(pyrrole propionic acid) hybridsScienceDirect: S0956566313005629
- The effects of long-term exposure to a 2450 MHz electromagnetic field on growth and pubertal development in female Wistar ratsInformahealthcare: Source
- A Pilot Study Comparing the Effect of Flaxseed, Aromatase Inhibitor, and the Combination on Breast Tumor BiomarkersTandfonline: Source
- CONCENTRACOES SéRICAS DE INSULINA NO PóS-PARTO RECENTE DE VACAS DE CORTE DE DIFERENTES GENóTIPOS CRIADAS NO SUL DO BRASILEmbrapa: Source
- Negative Energy Balance Induced by Paradoxical Sleep Deprivation Causes Multicompartmental Changes in Adipose Tissue and Skeletal MuscleCepebr:Source
- The effect of topiramate and lamotrigine on rat bone mass, structure and metabolism.Pubmed:24629477
- Effects of Resveratrol on Ovarian Morphology, Plasma Anti-Mullerian Hormone, IGF-1 Levels, and Oxidative Stress Parameters in a Rat Model of Polycystic Ovary SyndromePubmed:25667201
- Effects of sericin on the testicular growth hormone/insulin-like growth factor-1 axis in a rat model of type 2 diabetesPubMed: 26379831
- The effects of self-assembling peptide RADA16 hydrogel on malignant phenotype of human hepatocellular carcinoma cellPubMed: 26628972
- The use of herb mix and lucerne to increase growth rates of dairy heifersSystem: Files
- Maternal Nutrition with Β-Hydroxy-Β-Methylbutyrate as Strong Determinants of the Development of Newborn Offspring in PigsJournals: 1000183
- The Protective Effects of Exclusive Enteral Nutrition Formulas on Growth Factor Expression and the Proximal Tibial Epiphyseal Growth Plate in a TNBS-Induced IBD Rat ModelPubMed: 25708898
- Hypoxia-induced secretion of IL-12 from adipose-derived mesenchymal stem cell promotes growth and cancer stem cell properties of Burkitt lymphomaPubMed: 26695151
- RELATIONSHIP OF RESIDUAL FEED INTAKE WITH BLOOD METABOLITES AND HORMONES IN SAHIWAL FEMALE CALVESWp-Content: Uploads
- CaracterizaTeses: Disponiveis
- Melatonin Mediates Monochromatic Light‐induced Insulin‐like Growth Factor 1 Secretion of Chick Liver: Involvement of Membrane ReceptorsPubmed:27128575
- Protective effect of vitamin D against hyperoxia‐induced lung injury in newborn ratsPubmed:27291304
- A single bout of resistance exercise improves memory consolidation and increases the expression of synaptic proteins in the hippocampusPubmed:27008926
- Cigarette Smoke Delays Regeneration of the Olfactory Epithelium in MicePubmed:27003941
- Comparison of the effect of a standard inclusion level of inorganic zinc to organic form at lowered level on bone development in growing male Ross broiler chickens journalprintahead:87
- Comparison of the Effect of a Standard Inclusion Level of Inorganic Zinc to Organic Form at Lowered Level on Bone Development in Growing Male Ross Broiler Chickensview:87
- Effects of acute exercise on salivary free insulin-like growth factor 1 and interleukin 10 in sportsmen.pubmed:27605972
- Paradoxical Sleep Deprivation Causes Cardiac Dysfunction and the Impairment Is Attenuated by Resistance Training.pubmed:27880816
- Expression of Iron-Related Proteins Differentiate Non-Cancerous and Cancerous Breast Tumors.pubmed:28216608
- Chronic intermittent hypoxia disturbs insulin secretion and causes pancreatic injury via theMAPK signaling pathway.pubmed:28177762
- Resistance Exercise Reduces Seizure Occurrence, Attenuates Memory Deficits and Restores BDNF Signaling in Rats with Chronic Epilepsyarticle:10.1007
- GH蛋白诱导鸡原代成肌细胞表达IGF1条件优化10697
- Assessment of feeding varying levels of Metabolizable energy and protein on performance of transition Murrah buffaloespubmed:28785907
- Mesenchymal stem cells promote endothelial progenitor cell proliferation by secreting insulin‑like growth factor‑1pubmed:28627605
- Resistance Exercise Reduces Seizure Occurrence, Attenuates Memory Deficits and Restores BDNF Signaling in Rats with Chronic Epilepsy pubmed:28078614
- Effect of Dietary Phytase Supplementation on Bone and Hyaline Cartilage Development of Broilers Fed with Organically Complexed Copper in a Cu-Deficient Dietarticle:10.1007
- Effect of Zinc Level and Source (Zinc Oxide Vs. Zinc Glycine) on Bone Mechanical and Geometric Parameters, and Histomorphology in Male Ross 308 Broiler Chicken10.159:1806-9061-2016-0285
- Studies on quality attributes of skimmed colostrum powderP-ISSN: 2349–8528
- Effects of low-intensity pulsed ultrasound (LIPUS)-pretreated human amnion-derived mesenchymal stem cell (hAD-MSC) transplantation on primary ovarian insufficiency in rats10.1186/s13287-017-0739-3
- A metabolite of leucine (β-hydroxy-β-methylbutyrate) given to sows during pregnancy alters bone development of their newborn offspring by hormonal modulation10.1371/journal.pone.0179693
- A DPP-IV-resistant glucagon-like peptide-2 dimer with enhanced activity against radiation-induced intestinal injurypubmed:28522195
- Effects of Bariatric Surgery on Change of Brown Adipocyte Tissue and Energy Metabolism in Obese Micepubmed:28853013
- Effect of dietary protein intake on the body composition and metabolic parameters of neutered dogspubmed:29152244
- Involvements of γδT Lymphocytes in Acute and Chronic Skin Wound Repair.pubmed:28540539
- Rosiglitazone Exerts an Anti-depressive Effect in Unpredictable Chronic Mild-Stress-Induced Depressive Mice by Maintaining Essential Neuron Autophagy and Inhibiting Excessive Astrocytic Apoptosis.pubmed:28959186
- Various LED Wavelengths Affected Myofiber Development and Satellite Cell Proliferation of Chick Embryos via the IGF-1 Signaling Pathway.pubmed:28708285
- An enriched environment restores hepatitis B vaccination-mediated impairments in synaptic function through IFN-γ/Arginase1 signalingPubmed:29627530
- Generation of GHR-modified pigs as Laron syndrome models via a dual-sgRNAs/Cas9 system and somatic cell nuclear transferPubmed:29482569
- Subsequent somatic axis and bone tissue metabolism responses to a low-zinc diet with or without phytase inclusion in broiler chickensPubmed:29373588
- Evaluation of serum insulin-like growth factor-1 and 26S proteasome concentrations in healthy dogs and dogs with chronic diseases depending on body condition …10.1016:j.rvsc.2018.04.009
- Effects of Amlodipine on Bone Metabolism in Orchidectomised Spontaneously Hypertensive RatsPubmed:29898457
- Dietary supplementation for Santa Inês hair ewes on pasture at pre-and postpartum periods: dry matter intake, digestibility, milk production, and mineral metabolismPubmed:29931604
- 26S proteasome and insulin-like growth factor-1 in serum of dogs suffering from malignant tumorsPubmed:29755191
- Effects of Intrauterine Growth Retardation on Growth, Meat Quality and Muscle Fiber Composition of Pigs.:
- Circulating concentrations of insulin like growth factor-1 in female dogs with spontaneous mammary tumours10.21521:mw.6054
- Nucleoside reverse transcriptase inhibitor-induced rat oocyte dysfunction and low fertility mediated by autophagyPubmed:29423092
- Effect of porcine somatotropin on metabolism, testicular size and sperm characteristics in young boars10.1590:1678-4162-9481
- Fermented corn-soybean meal elevated IGF1 levels in grower-finisher pigsPubmed: 30203098
- Maternal HMB treatment affects bone and hyaline cartilage development in their weaned piglets via the leptin/osteoprotegerin systemPubmed: 30659706
- The therapeutic effects of nicotinamide in hepatocellular carcinoma through blocking IGF-1 and effecting the balance between Nrf2 and PKBPubmed: 30784932
- Association between Insulin-Like Growth Factor-I Levels and the Disease Progression and Anemia in Visceral LeishmaniasisPubmed: 30761980
- Light-dark rhythms during incubation of broiler chicken embryos and their effects on embryonic and post hatch leg bone developmentPubmed: 30682088
- Mel1c Mediated Monochromatic Light-Stimulated IGF-I Synthesis through the Intracellular Gαq/PKC/ERK Signaling PathwayPubmed: 30987295
- Serum and seminal plasma IGF-1 associations with semen variables and effect of IGF-1 supplementation on semen freezing capacity in buffalo bullsPubmed: 30914211
- Melatonin mediates monochromatic green light-induced satellite cell proliferation and muscle growth in chick embryoPubmed: 31059537
- Preventive effect of dried plum extract against dexamethasone-induced osteoporosis in male rats through inhibiting cathepsin-K activity, lipogenesis and …
- Alterations in haemato-biochemical profile following by-pass nutrients supplementation in early lactating Murrah buffaloes
- Effect of betaine supplementation on growth performance, nutrient intake and expression of IGF-1 in Karan Fries heifers during thermal stressPubmed: 31711708
- Effects of a diet enriched with eicosapentaenoic, docosahexaenoic and glutamine on cytokines as immunological markers for systemic inflammation in bitches before …Pubmed: 31637790
- The association between serum insulin-like growth factor 1 and cognitive impairments in patients with schizophreniaPubmed: 31839419
- BST Stimulation Induces Atrophy and Changes in Aerobic Energy Metabolism in Rat Skeletal Muscles—The Biphasic Action of Endogenous GlucocorticoidsPubmed: 32316389
- Fenugreek Stimulates the Expression of Genes Involved in Milk Synthesis and Milk Flow through Modulation of Insulin/GH/IGF-1 Axis and Oxytocin SecretionPubmed: 33081164
- Cytokine and Growth Factor Delivery from Implanted Platelet-Rich Fibrin Enhances Rabbit Achilles Tendon HealingPubmed: 32370144
- Is Dietary 2-Oxoglutaric Acid Effective in Accelerating Bone Growth and Development in Experimentally-Induced Intrauterine Growth Retarded Gilts?Pubmed: 32331362
- Peripheral concentrations of metabolic and inflammatory indicators during transition period and their relationship with postpartum clinical endometritis in dairy …
- Changes and Risk Factors of Skeletal Muscle Mass and Strength in Patients with Type 2 Diabetes over 60 Years Old: A Cross-Sectional Study from China
- Therapeutic effects of organic zinc on reproductive hormones, insulin resistance and
- INFLUENCE OF OMEGA–3 RICH FATTY ACID ENRICHED FEED ON BIOCHEMICAL MARKERS AND POST PARTUM REPRODUCTIVE PERFORMANCE OF …
- Prospects on the Potential In Vitro Regenerative Features of Mechanically Treated-Adipose Tissue for Osteoarthritis Care33469783
- Adipose-Derived Stem Cells Improve the Aging Skin of Nude Mice by Promoting Angiogenesis and Reducing Local Tissue Water33428732
- Effect of alfalfa hay and starter feed supplementation on caecal microbiota and fermentation, growth, and health of yak calves33610512
- Handling Associated with Drenching Does Not Impact Survival and General Health of Low Birth Weight Piglets. Animals 2021, 11, 40433562568
- New design to remove leukocytes from platelet-rich plasma (PRP) based on cell dimension rather than density33842739
- The Paracrine Effect of Adipose-Derived Stem Cells Orchestrates Competition between Different Damaged Dermal Fibroblasts to Repair UVB-Induced Skin?¡33381190
- The Protective Role of Alpha-Ketoglutaric Acid on the Growth and Bone Development of Experimentally Induced Perinatal Growth-Retarded Piglets33435211
- Comparative study on genital status, energy balance and mineral content of swamp buffalo (Luit) heifers and cows under organized system of rearing in Assam?¡
- The Association of Pre-Pregnancy BMI On Leptin, Ghrelin, Adiponectin, and IGF-1 In Breast Milk, A Case Control Study34348809
- Effects of Concentrate and Bypass Fat Supplementations on Growth Performance, Blood Profile, and Rearing Cost of Feedlot Buffaloes34359233
- Association of Salivary IGF and IGF/IGFBP-3 Molar Ratio with Cervical Vertebral Maturation Stages from Pre-Adolescent to Post-Adolescent Transition Period—A …Pubmed:35564566